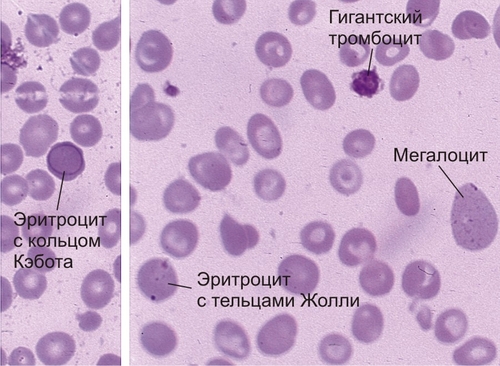

КАТЕГОРИИ:
Архитектура-(3434)Астрономия-(809)Биология-(7483)Биотехнологии-(1457)Военное дело-(14632)Высокие технологии-(1363)География-(913)Геология-(1438)Государство-(451)Демография-(1065)Дом-(47672)Журналистика и СМИ-(912)Изобретательство-(14524)Иностранные языки-(4268)Информатика-(17799)Искусство-(1338)История-(13644)Компьютеры-(11121)Косметика-(55)Кулинария-(373)Культура-(8427)Лингвистика-(374)Литература-(1642)Маркетинг-(23702)Математика-(16968)Машиностроение-(1700)Медицина-(12668)Менеджмент-(24684)Механика-(15423)Науковедение-(506)Образование-(11852)Охрана труда-(3308)Педагогика-(5571)Полиграфия-(1312)Политика-(7869)Право-(5454)Приборостроение-(1369)Программирование-(2801)Производство-(97182)Промышленность-(8706)Психология-(18388)Религия-(3217)Связь-(10668)Сельское хозяйство-(299)Социология-(6455)Спорт-(42831)Строительство-(4793)Торговля-(5050)Транспорт-(2929)Туризм-(1568)Физика-(3942)Философия-(17015)Финансы-(26596)Химия-(22929)Экология-(12095)Экономика-(9961)Электроника-(8441)Электротехника-(4623)Энергетика-(12629)Юриспруденция-(1492)Ядерная техника-(1748)
Дисэритропоэтические анемии
|
|
|
|
Количество клеток в костном мозге при дисэритропоэтических анемиях нормальное или повышенное, но продукция эритроцитов снижена, что связано с нарушенным или недостаточным эритропоэзом. Чаще эти анемии бывают приобретёнными.
Выделяют следующие причины вторичных дисэритропоэтических анемий.
● Нарушение синтеза ДНК: недостаточность или нарушение всасывания витамина В12 и фолиевой кислоты (мегалобластные анемии).
● Нарушение синтеза гемоглобина:
нарушение синтеза гема (дефицит железа);
нарушение метаболизма железа (сидеробластные анемии при хронических заболеваниях, туберкулёзном поражении костного мозга);
нарушение синтеза глобина (талассемии).
Мегалобластные анемии
Типичный пример анемий этой группы — мегалобластные анемии, обусловленные дефицитом B12 и фолиевой кислоты. Причины дефицита этих веществ — их недостаток в пище, нарушение всасывания, транспорта, повышение потребности.
Витамин B12 и фолиевая кислота действуют как коферменты, они необходимы для нормального функционирования и деления клеток. При отсутствии витамина B12 и фолиевой кислоты снижение синтеза ДНК приводит к мегалобластному гемопоэзу, атрофии активно регенерирующей в нормальных условиях слизистой оболочки желудочно-кишечного тракта (атрофическому глосситу, изъязвлению слизистой оболочки полости рта, хроническому атрофическому гастриту, атрофии ворсин тонкой кишки), нарушению созревания зародышевых клеток у лиц обоих полов (бесплодию). Наблюдают неврологическую симптоматику, поскольку витамин B12 необходим для образования миелиновой оболочки нервов. Наиболее характерно подострое комбинированное поражение в виде перемежающейся демиелинизации длинных пирамидных путей и задних рогов среднегрудного отдела спинного мозга. Очаговую демиелинизацию обнаруживают в крупных периферических нервах и полушариях головного мозга.
При одновременной недостаточности витамина B12 и фолиевой кислоты в периферической крови возникает панцитопения. Повышен средний объём эритроцитов, наблюдают анизоцитоз, макроцитоз, пойкилоцитоз. В развёрнутой стадии в эритроцитах появляются ядра и тельца Хауэлла–Жолли. Количество ретикулоцитов уменьшено. Отмечают нейтропению, появление крупных нейтрофилов (макрополицитов) с гиперсегментированными ядрами, содержащими не менее шести долей. Количество тромбоцитов также уменьшено, иногда при тяжёлой тромбоцитопении появляется пурпура (геморрагический синдром).
Костный мозг трубчатых костей становится красным, приобретает вид «малинового желе». Все элементы гемопоэза повреждены, наблюдают эритроидную гиперплазию, мегалобластные изменения, сохранение ядер в дифференцирующихся клетках, полиплоидию и фрагментацию ядер (рис. 9-3). Синтез гемоглобина в развивающихся эритробластах нарушен меньше. Появляются гигантские метамиелоциты, эритрофагия (фагоцитоз и разрушение аномальных эритробластов макрофагами), гемосидероз. Часто отмечают небольшое увеличение селезёнки, связанное с интенсивным разрушением эритроцитов или экстрамедуллярным мегалобластным гемопоэзом.
Рис. 9-3. В12-дефицитная анемия. Окраска по Романовскому–Гимзе (x600).
Пернициозная анемия — один из вариантов мегалобластных анемий (pernicious — злокачественное течение). Она развивается при хроническом атрофическом аутоиммунном гастрите (гастрите типа А) и после гастрэктомии.
Основную роль в развитии болезни играет недостаточность внутреннего фактора, вырабатываемого, наряду с соляной кислотой, париетальными клетками в фундальном отделе желудка. К снижению синтеза внутреннего фактора приводит аутоиммунная реакция против него или париетальных клеток, вызывающая атрофию слизистой оболочки желудка.
Наличие аутоиммунного процесса можно доказать рядом фактов. Так, в сыворотке крови и желудочном соке пациентов обнаружены три типа антител.
● У 90% пациентов — париетальные каналикулярные антитела, (реагирующие с микроворсинками каналикулярной системы париетальных клеток).
● У 60% — блокирующие антитела (блокируют образование комплекса B12 с внутренним фактором).
● У 50% — связывающие антитела, реагирующие с комплексом B12 — внутренний фактор и препятствующие его присоединению к эпителию подвздошной кишки.
Кроме того, лица, страдающие пернициозной анемией, а также их родственники часто заболевают аутоиммунным тиреоидитом, болезнью Аддисона и сахарным диабетом I типа. Наконец, частота определения в сыворотке антител к внутреннему фактору у пациентов возрастает при сочетании с другими аутоиммунными заболеваниями.
Неадекватное поступление фолиевой кислоты с пищей бывает при хроническом алкоголизме, у пожилых лиц и недоношенных младенцев, вскармливаемых коровьим молоком. Нарушение всасывания фолиевой кислоты вызывают глютеновая энтеропатия, гастрэктомия, тяжёлая форма болезни Крона, диффузная лимфома тонкой кишки и приём ряда лекарств. Дефицит фолиевой кислоты может быть вызван наследственным нарушением транспорта фолата в слизистой оболочке кишки.
Повышенная потребность в фолиевой кислоте возникает при беременности, болезнях с высокой гемопоэтической активностью (например, хронических гемолитических состояниях) и запущенных злокачественных опухолях, когда для интенсивного синтеза ДНК необходимо дополнительное количество фолиевой кислоты. Многочисленные лекарственные средства (метотрексат, триметоприм, триамтерен, сульфасалазин) действуют как антагонисты фолиевой кислоты.
Железодефицитная анемия
Железодефицитная анемия — один из наиболее частых видов анемий. Уровень железа в плазме крови в норме составляет 13–32 мкмоль/л, 95% этого количества находится в форме трансферрина. Уровень железа в плазме оценивают по содержанию ферритина в сыворотке крови. Отрицательный баланс железа возникает при избыточной потере и/или недостаточном поступлении или усвоении.
В организме человека нет механизма, регулирующего выделение железа. Контроль содержания железа возможен только интенсивностью его всасывания в двенадцатиперстной кишке и проксимальном отделе тощей кишки. В организме — 3–4 г железа, около 70% из них — в геме гемоглобина, 5% железа — в миоглобине. Небольшое количество железа включено в клеточные цитохромы, каталазу, пероксидазу, ксантиноксидазу и рибонуклеотидредуктазу. Остальное железо (0,3–1,4 г) сохраняют макрофаги селезёнки, костного мозга и печени, а также клетки разных органов, в частности, гепатоциты.
Основная причина железодефицитной анемии — хроническая кровопотеря. Если больной ежедневно теряет 10–15 мл крови, содержащих 5–7 мг железа, это соответствует максимальному суточному количеству железа, получаемого при нормальном питании. Тяжёлые менструальные кровотечения, скрытые кровоизлияния (особенно из пептических язв или изъязвлённых опухолей), глистная инвазия часто приводят к железодефицитной анемии.
Дефицит железа также может быть вызван недостаточным его поступлением с пищей и мальабсорбцией (нарушением всасывания в тонкой кишке) при глютеновой энтеропатии, ахлоргидрии, после гастрэктомии.
Морфологическая картина. В пунктате костного мозга — отрицательная реакция Перлса. Выявляют эритроидную гиперплазию, гипохромию и микроцитоз эритроцитов, пойкилоцитоз, при тяжёлом дефиците железа — кольцевидно окрашенные и палочковидные эритроциты, овалоциты. Внекостномозговое кроветворение нехарактерно.
При латентной железодефицитной анемии картина крови может быть нормальной, но уровень железа в сыворотке снижен.
Изменения в других органах и тканях обусловлены истощением железосодержащих ферментов и хронической гипоксией. Ногти становятся бороздчатыми, полосатыми и ломкими, приобретая со временем ложкообразную вогнутую форму — койлонихия. Могут возникать атрофический гастрит, атрофический глоссит, трещины в углах рта и дисфагия (нарушение глотания) из-за складчатой деформации слизистой оболочки в шейных отделах пищевода. Ахлоргидрия при гастрите усиливает дефицит железа.
Анемии вследствие нарушения метаболизма железа проявляются нарушением его утилизации. Тяжёлые хронические инфекции, ревматоидный артрит, системная красная волчанка, злокачественные опухоли вызывают нарушение усвоения железа и микроцитарную анемию. Причина анемии — блокада освобождения железа из макрофагов, в результате железо не может быть усвоено в костном мозге, это задерживает созревание эритробластов. Количество сывороточного ферритина соответствует норме или повышено. В костном мозге отмечают уменьшение эритропоэтической активности и небольшое укорочение продолжительности жизни эритроцитов. При хроническом воспалении подавление эритропоэза, нарушение депонирования и перемещения железа из мест хранения может быть связано с действием медиаторов воспаления (ИЛ-1, фактор некроза опухоли и др.).
Атрансферринемия — очень редкая анемия, связанная с нарушением транспорта железа. Она возникает при дефектах переноса железа из-за отсутствия трансферрина или его конформационных изменениях.
|
|
|
|
|
Дата добавления: 2015-06-04; Просмотров: 1900; Нарушение авторских прав?; Мы поможем в написании вашей работы!